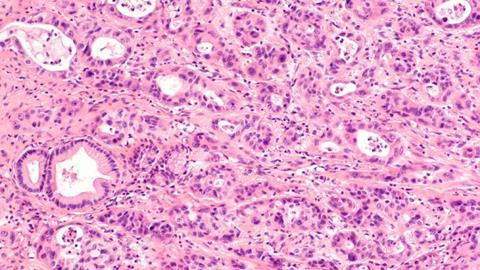
Image

Using tumour organoids, researchers have found a starting point for the development of a more refined PDAC drug.
Scientists at Weill Cornell Medicine have discovered a promising target for future pancreatic cancer treatments by using a drug screening system that models cancers using organoids.
The researchers tested thousands of compounds on their pancreatic tumour organoids, which contain a common pancreatic cancer-driving mutation. An existing drug was found to powerfully suppress the organoids’ growth. The researchers also discovered that the cancer-driving mutation in the organoids forces the abnormally high production of cholesterol, which the drug largely reverses.
The study’s co-senior author Dr Todd Evans said: “Our findings identify hyperactive cholesterol synthesis as a vulnerability that may be targetable in most pancreatic cancers.” Evans is the vice chair for research in surgery, the Peter I Pressman MD Professor in Surgery, a member of the Hartman Institute for Therapeutic Organ Regeneration at Weill Cornell Medicine, and a member of the Sandra and Edward Meyer Cancer Center.
Co-senior author Dr Shuibing Chen, director of the Center for Genomic Health, the Kilts Family Professor Surgery and a member of the Hartman Institute for Therapeutic Organ Regeneration at Weill Cornell Medicine, added: “This study also highlights the value of using genetically well-defined organoids to model cancer and discover new treatment strategies.”
Tumour Organoids
Organoids are now popular tools for studying tissues in health and disease. One of their advantages is that they can model specific tumour types with their cancer-driving gene mutations. These tumour organoids have the potential to model human cancers better than any animal model when they are derived from human tissue.
In the study, the researchers set up an organoid-based automated drug-screening system for pancreatic ductal adenocarcinoma (PDAC). The organoids, derived from normal mouse pancreatic tissue, were engineered to contain sets of mutations known to drive human pancreatic tumours. All the organoids contained KrasG12D, the mouse version of a cancer-driving mutant gene found in most cases of PDAC.
The scientists tested a library of over 6,000 compounds, including FDA-approved drugs, on the organoids and found several that could substantially disrupt their growth. The most effective drug was perhexiline maleate, an older drug used to treat angina. A modest dose of the drug blocked growth in all the KrasG12D-containing organoids, destroying some of them within days, yet had no adverse effect on healthy organoids without the mutation.
In mouse and human PDAC-derived tumour organoids transplanted into mice, and in human tumour organoids carrying other types of Kras mutation, the drug had similar effects.
Targeting cholesterol
The researchers compared gene activity patterns in treated and untreated organoids and found that cancer associated mutant Kras greatly boosts the production of cholesterol in organoid cells and that perhexiline maleate opposes this effect by inhibiting a key cholesterol metabolic pathway regulatory factor called SREBP2.
Cholesterol is crucial for producing new cells and is a promoter of cell survival. It is known to be a significant sustainer of malignant growth for some other tumours. The study’s results indicate that targeting it could be an effective new treatment strategy against PDAC.
Also, perhexiline maleate’s effectiveness in human organoids with numerous different Kras mutations suggests that turbo-charged cholesterol synthesis can be a general treatment target in KRAS-mutant cancers.
“We hope that our cholesterol-targeting strategy will be independent of particular KRAS mutations and will make it hard for treated tumours to evolve resistance,” said Dr Evans.
Currently, the team plans to use perhexiline maleate as a starting point for the development of a more refined candidate PDAC drug, and as a laboratory tool for studying cholesterol synthesis in PDAC and other cancers. Although perhexiline malate is prescribed for angina in Australia and other countries, it can have serious side effects, like liver damage and peripheral nerve damage. It was withdrawn from several European markets in the 1980s and was never approved in the United States.
“We want a better compound for cancer treatment,” said Dr Chen. “The simplicity of the drug’s chemical structure suggests that it probably can be modified to improve its potency, safety, bloodstream half-life and other properties.”
The study was published in Cell Stem Cell.


